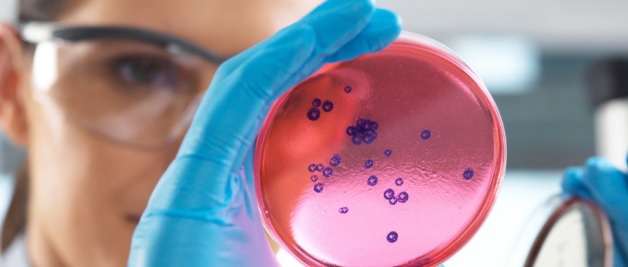

Two experts explain why it is so difficult
ANALYSIS | ALISTAIR FARLEY & HELEN SMITH | The discovery of antibiotics is one of the greatest medical breakthroughs of the 20th century. Before antibiotics, childbirth, a urinary tract infection, or a simple cut could lead to death from infection.
Antibiotics, a type of antimicrobial, have made many modern medical procedures possible, and now the global healthcare system relies on them.
Due to increasing antimicrobial use, microbes – such as bacteria, fungi and parasites – have developed the ability to resist the action of these medicines. The result is that common infections that were once easily treatable are becoming more difficult to cure and in some cases can be fatal.
Following the development of penicillin in the mid-1940s, many new classes of antibiotics were developed. However, since the 1980s there has been little investment into the development of new ones and very few have been approved.
There’s an urgent need for new antibiotics that work against drug-resistant bacteria. Drug-resistant infections are expected to claim more than 39 million lives between now and 2050 without further action.
So why are so few new antibiotics being successfully developed for medical use?
Investment in new drugs
Many pharmaceutical companies have left this area of research. On top of this, finding new and different types of antibiotics that will not be quickly rendered ineffective by existing antimicrobial resistance (AMR) is a formidable challenge.
Developing a new medicine is a complex, extremely expensive and time consuming endeavour. It can take 10 to 15 years from initial discovery all the way to approval, and costs more than US$1 billion.
Most existing antibiotics are cheap and readily available. Any new antibiotics are generally considered “last resort” drugs, used only when all other treatment options have been exhausted. This is to prevent the development of resistance against them.
This means that the return on investment is much lower for antibiotics compared to medicines for many other illnesses.
Pharmaceutical companies are therefore unlikely to recover the costs associated with developing a new antibiotic at the end of a lengthy research process.
Testing what works safely
When searching for new potential antibiotics, researchers screen extracts and compound libraries and also use Artificial Intelligence (AI) approaches to look for those that show promising antimicrobial activity.
The scientists then refine and improve the initial findings in the lab by testing these against infection-causing pathogens. At the same time they make sure the compounds will not be harmful to humans.
For an antibiotic to work in a patient, it must reach the areas of the body where the illness-causing pathogen is located in high enough concentrations to clear the infection. At the same time it must minimise any side effects.
Scientists need to modify many parameters of molecules for safety and efficacy prior to undertaking the next stages of development.
After early-stage development, lead compounds must undergo a series of human clinical trials under carefully controlled conditions. This is to make sure that these are first and foremost safe and effective at treating the disease.
Recent developments
Universities and small companies are now responsible for much of the discovery and early-stage antibiotic development.
At the Ineos Oxford Institute for antimicrobial research we are developing new classes of antibiotics and new combination therapies.
In a combination therapy, two or more drugs are given to a patient at the same time, with each drug having a particular role.
One drug is the antibiotic, such as penicillin, and kills the bacteria.
The second drug targets the resistance mechanism that bacteria have evolved to evade the antibiotic and acts as an antibiotic guardian.
By targeting the resistance mechanism, the second drug protects the antibiotic from destruction and allows the antibiotic to clear the infection and cure the patient.
A recent potential combination therapy developed by us involved two guardian molecules being administered with one existing antibiotic. This triple combination showed promise against a broad range of drug-resistant bacteria.
Our work, however, cannot be done in isolation. Commitment from governments, the pharmaceutical industry and global public health bodies is required to support and sustain the antibiotic pipeline.
One strategy, in which the UK is a global leader, is to create a subscription-style model for purchasing antibiotics which is not linked to the number of antibiotics sold.
Healthcare providers would pay the pharmaceutical company a fixed fee for the antibiotics based on their usefulness, and not the amount used.
This separates demand from profit, making it more economically viable for companies to develop new antibiotics for global public health.
*****
Alistair Farley is Science Lead, University of Oxford and Helen Smith is a Postdoctoral Research Associate, University of Oxford
Source: The Conversation
The Independent Uganda: You get the Truth we Pay the Price